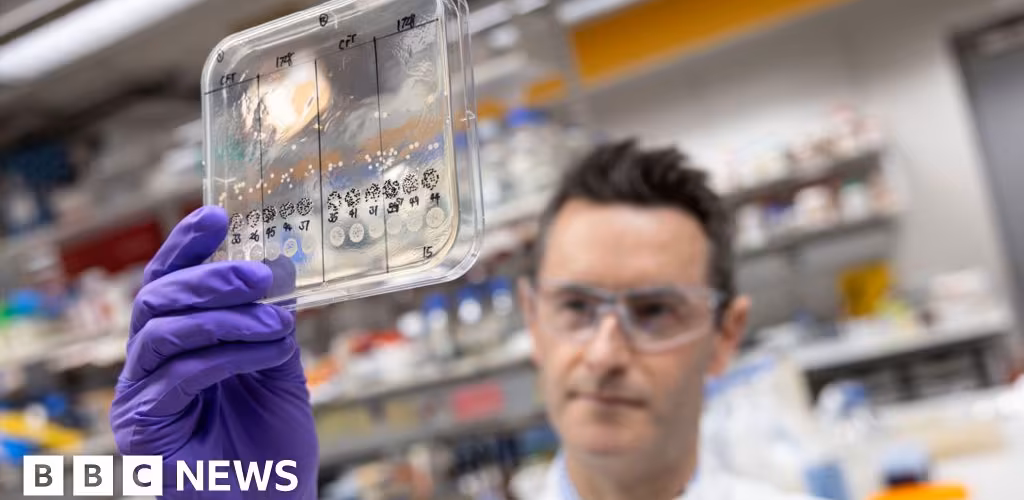

Major UK project launched to tackle drug-resistant superbugs with AI
BBC | 18.11.2025 13:10
The UK is to use artificial intelligence (AI) to tackle the rising numbers of infections that have become resistant to treatment.
The project - a collaboration between the Fleming Initiative and the pharmaceutical company GSK - is a battle between superbugs and supercomputers.
It aims to speed up the discovery of fresh antibiotics and deliver new ways of killing other threats, including deadly fungal infections.
Overusing antibiotics drives bacteria to evolve resistance to infections, which means new drugs are a priority.
Drug-resistant infections are a growing problem – one known as "the silent pandemic".
Superbugs are now thought to directly kill around one million people a year worldwide and contribute to the deaths of millions more. Those figures are predicted to continue to grow.
The collaboration will spend £45m on six fields of research.
"This represents the single biggest investment in a UK antibiotic project I'm aware of," says Dr Andrew Edwards from Imperial College London.
He will be targeting AI at a tricky group of infections, called Gram-negative bacteria, that includes well known bugs such as E. coli and Klebsiella pneumoniae.
These species have an extra outer layer they use to control what gets in and out of a bacterium. Gram-negative species can block antibiotics from getting in and rapidly pump out those that penetrate the bacterial defences – making them tough to treat.
The team will be performing experiments using molecules with different chemical structures and recording what can get inside and stay inside these bacteria.
This data will then be fed into the AI so it can learn what it takes for an antibiotic to persist inside a Gram-negative bacterium.
"The sort of AI that people are using routinely today is built on the sum total of information on the internet - it doesn't just produce answers out of thin air," Dr Edwards told the BBC.
"If you want to make progress, you have to have data," he says.
The aim is to convert years of research, if done by hand, into a simple job for a computer.
Then once the chemical code has been cracked, it will guide scientists on how to modify potential antibiotics to bypass the organism's defences.
Dr Edwards said there were cases coming out of the conflict in Ukraine now where infections could not be treated with any antibiotic.
"That means that limbs have to be amputated. I would say it's a glimpse into the future, but it's happening right now, it's a pretty horrific thought."
So can AI outpace bacterial evolution?
"That's a very good question, I think what we've seen is that if we can get a few good antibiotics, then we'll be back on on the front foot and then I think we can keep things in check," says Dr Edwards.

The Fleming Initiative is named after Alexander Fleming, who discovered penicillin in 1928 and started the antibiotic age.
Even by the time he won the Nobel Prize in Physiology or Medicine 80 years ago, he had warned of the dangers of resistance.
Alison Holmes, the director of the Fleming Initiative, said antibiotics were "one of the greatest health resources that has been squandered" and we should all think of how much we owe to antibiotics.
"Whether it's that time we stepped on a nail and or got cellulitis following an insect bite or our C-section wound, or our UTI, or our STI - we all depend on them," she said.
The collaboration will also use AI like a weather forecast to predict how superbugs emerge and spread.
And the project is also looking beyond bacteria to use AI to tackle the rise of deadly fungal infections, starting with Aspergillus mould.
Its spores are normally harmless, but can become deadly in people with weakened immune systems.
Tony Wood, the chief scientific officer at GSK, said: "We will open up new approaches for the discovery of novel antibiotics as well as anticipate and outpace the development of resistance to transform the treatment and prevention of serious infections."
Researchers in the US and Canada have already started using AI to shortlist drugs or even design antibiotics from scratch to target drug-resistant bacteria like gonorrhoea.
Data for the UK suggests nearly 400 new antibiotic-resistant infections are being detected every week.









